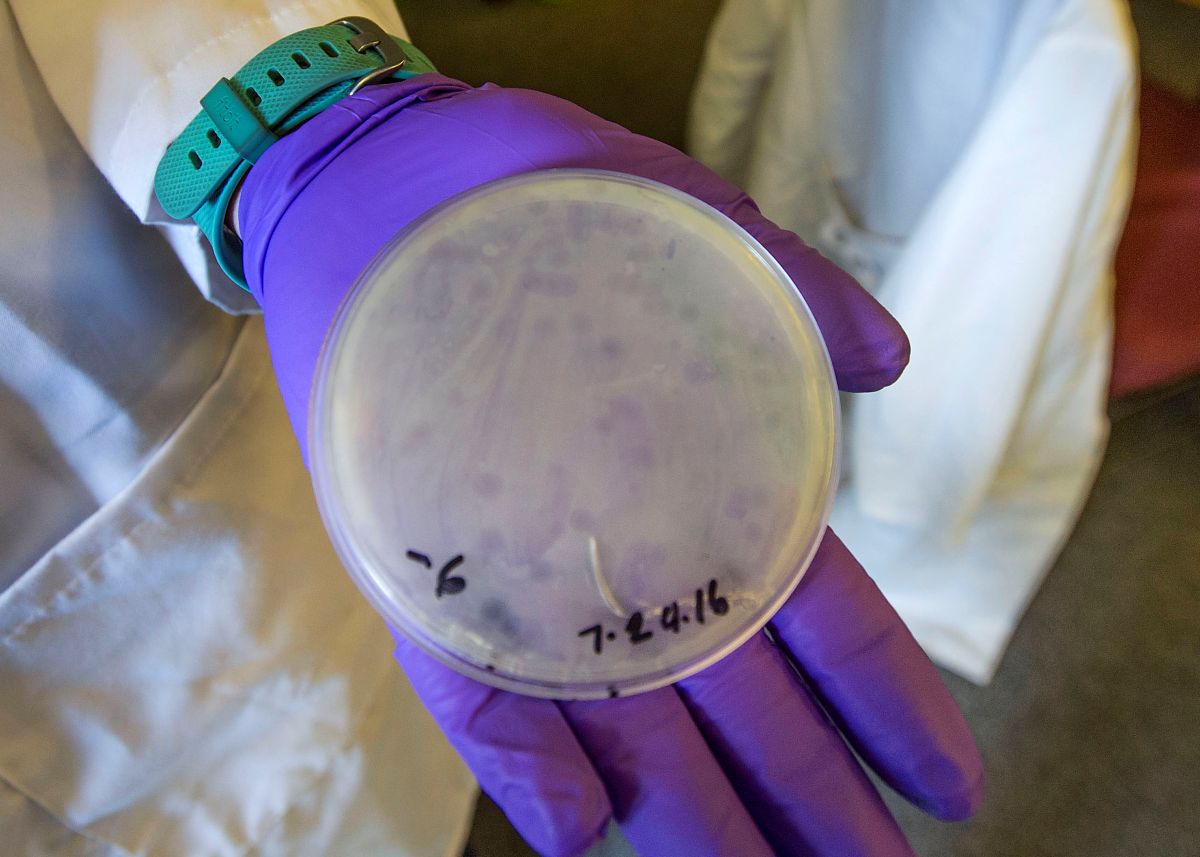

Virus Infection Lab
The study of viruses shapes our understanding of genetics and biotechnology. Scientists at Brookhaven National Laboratory developed the T7 expression system, a viral replication “machine” that drives protein production in bacterial cells. Students will use T7 bacteriophage to understand virus life cycle and plaque formation. They’ll dilute a T7 phage culture and infect E.coli. To determine virus infectivity, students will identify plaques, clear zones due to virus replication, and cell death bacterial lawn.
Vocabulary: bacteriophage, capsid, lytic cycle, aseptic, plaque
| Session Information | |
|---|---|
|
To request field trip dates, visit https://oepreg.bnl.gov/.
To explore programs listed in the ESBOCES Exploratory Enrichment catalog and to submit a BOCES contract request, please visit BOCES EE – Brookhaven Lab
Click here to download a teacher guide for this program.
Click here to download a sneak peak of this program for your students. We highly recommend providing this one-page preview to your students before attending your field trip.
NYS Learning Standards
New York State Science Learning Standards
| Disciplinary Core Ideas | Crosscutting Concepts | Science and Engineering Practices |
|---|---|---|
|
LS1.A: Structure and Function LS1.B: Growth and Development of Organisms |
Structure and Function Scale, Proportion, and Quantity |
N/A |
Next Generation English Language Arts Learning Standards
| Speaking and Listening | Language |
|---|---|
|
Comprehension and Collaboration |
Vocabulary Acquisition and Use |





